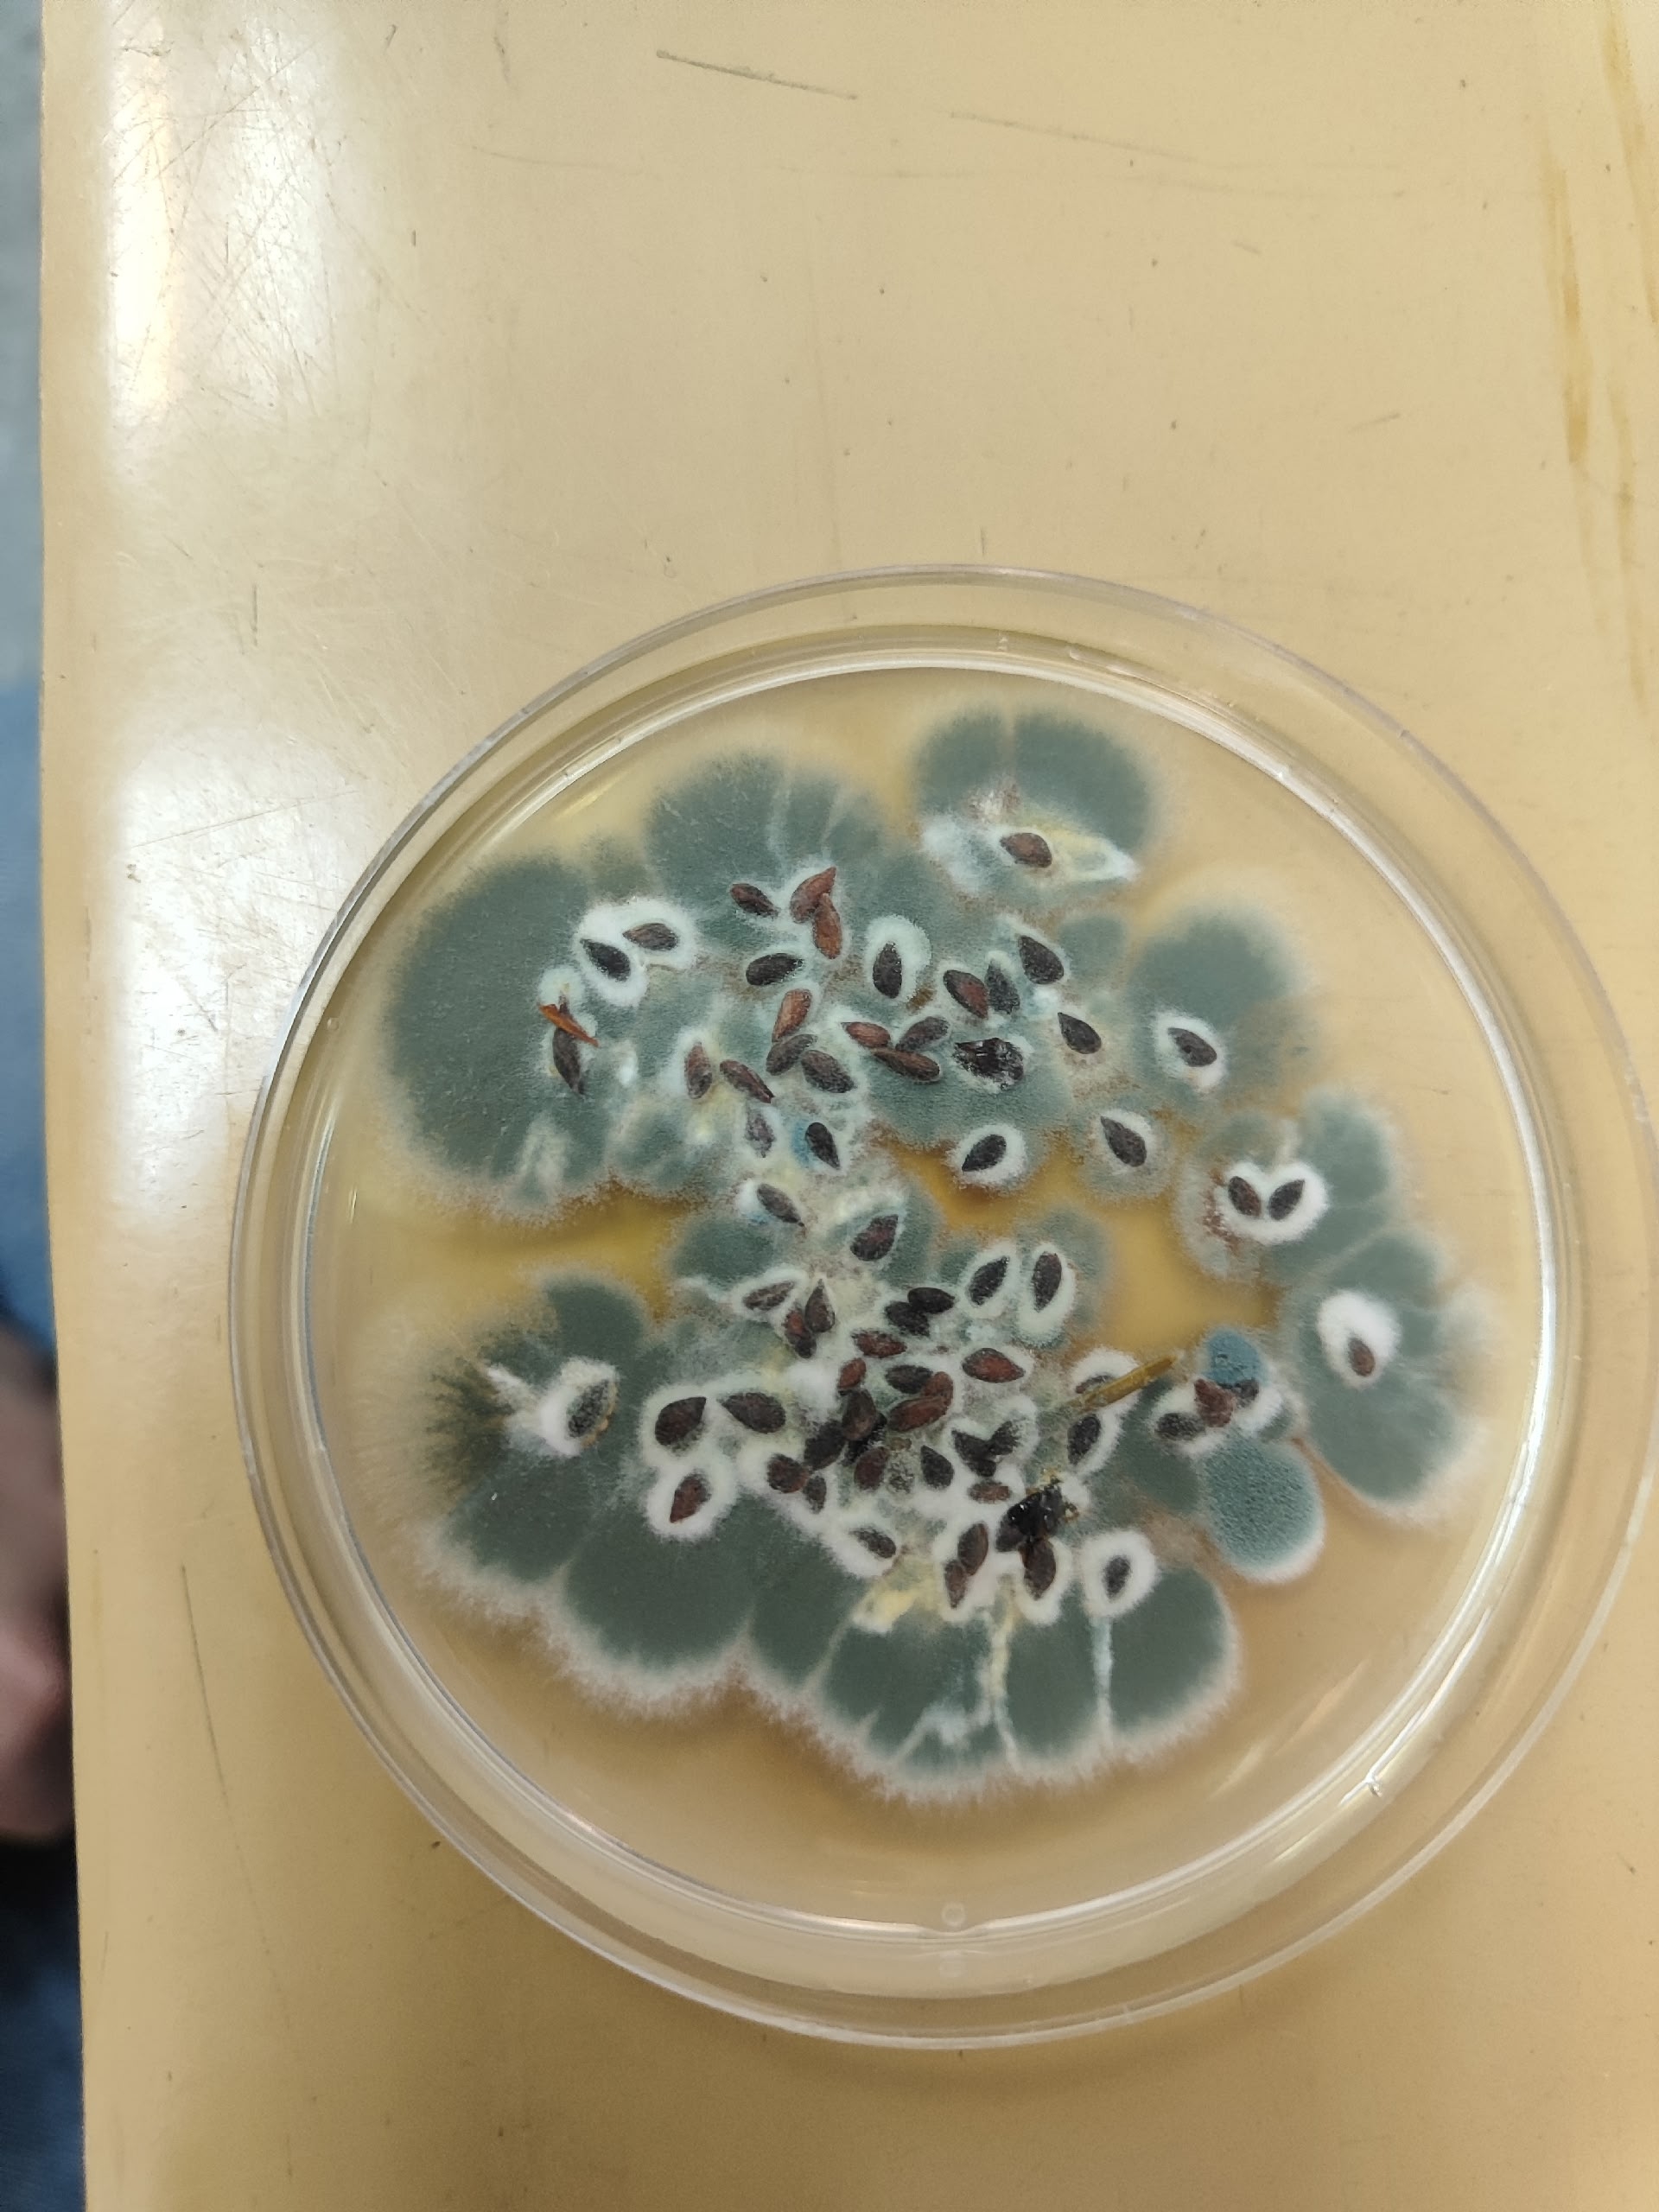

В апреле 2026 года в рамках выполнения государственного задания по направлению «Государственный мониторинг воспроизводства лесов» специалистами отдела «Тверская лесосеменная станция» филиала ФБУ «Рослесозащита» - «Центр защиты леса Тверской области» продолжена работа по оценке качества используемых при воспроизводстве лесов партий семян лесных растений.
За текущий месяц от заявителей на оценку поступили 5 партий семян ели европейской и 2 партии сосны обыкновенной. На 4 партии ели европейской заявителям выданы сертификаты качества семян лесных растений.
По итогам оценки партий семена 1 класса качества составили 6% (10,0 кг), 2 класса – 32% (50,0 кг) и 3 класса – 62% (99,3 кг). Некондиционные семена не отмечены.
Результат фитопатологического анализа семенного сырья показал, что 5 из 7 партий заражены патогенными грибами, что составляет 60% от общего числа поступивших семян. Основные возбудители – грибы родов Fusarium и Alternaria. Среди сапрофитных грибов выявлены грибы рода Mucor, Penicillium, Rhizopus, Stemphylium, Spicaria.
Работа по оценке качества семян лесных растений будет продолжена.